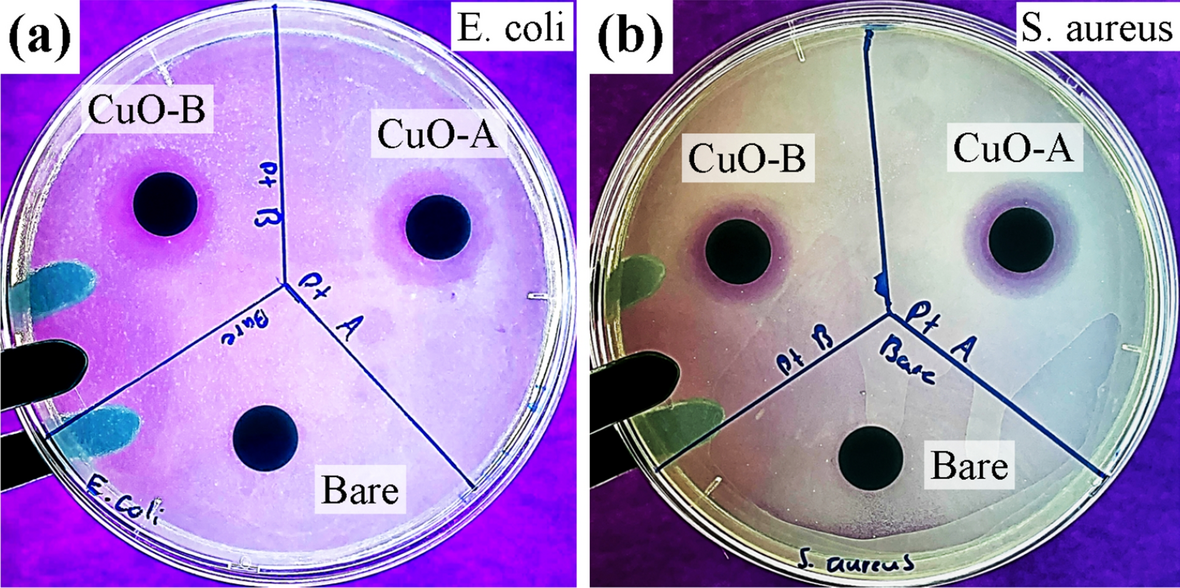
Figure 16

Figure 16

ZOI assays for HSR-Pt10Ir electrodes in NB. Two CuO coated electrodes (A and B) and an un-coated HSR-Pt10Ir electrode in (a) E. coli and (b) S. aureus were tested.
ZOI assays for HSR-Pt10Ir electrodes in NB. Two CuO coated electrodes (A and B) and an un-coated HSR-Pt10Ir electrode in (a) E. coli and (b) S. aureus were tested.